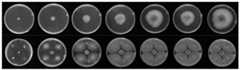

CN113388529B - Endophyte Penicillium ehrlichii of tea tree and application thereof - Google Patents
Endophyte Penicillium ehrlichii of tea tree and application thereofDownload PDFInfo
- Publication number
- CN113388529B CN113388529BCN202110687884.2ACN202110687884ACN113388529BCN 113388529 BCN113388529 BCN 113388529BCN 202110687884 ACN202110687884 ACN 202110687884ACN 113388529 BCN113388529 BCN 113388529B
- Authority
- CN
- China
- Prior art keywords
- plant
- ehrlichii
- endophyte
- penicillium
- anthracnose
- Prior art date
- Legal status (The legal status is an assumption and is not a legal conclusion. Google has not performed a legal analysis and makes no representation as to the accuracy of the status listed.)
- Active
Links
Images
Classifications
- A—HUMAN NECESSITIES
- A01—AGRICULTURE; FORESTRY; ANIMAL HUSBANDRY; HUNTING; TRAPPING; FISHING
- A01N—PRESERVATION OF BODIES OF HUMANS OR ANIMALS OR PLANTS OR PARTS THEREOF; BIOCIDES, e.g. AS DISINFECTANTS, AS PESTICIDES OR AS HERBICIDES; PEST REPELLANTS OR ATTRACTANTS; PLANT GROWTH REGULATORS
- A01N63/00—Biocides, pest repellants or attractants, or plant growth regulators containing microorganisms, viruses, microbial fungi, animals or substances produced by, or obtained from, microorganisms, viruses, microbial fungi or animals, e.g. enzymes or fermentates
- A01N63/30—Microbial fungi; Substances produced thereby or obtained therefrom
- A01N63/36—Penicillium
- A—HUMAN NECESSITIES
- A01—AGRICULTURE; FORESTRY; ANIMAL HUSBANDRY; HUNTING; TRAPPING; FISHING
- A01P—BIOCIDAL, PEST REPELLANT, PEST ATTRACTANT OR PLANT GROWTH REGULATORY ACTIVITY OF CHEMICAL COMPOUNDS OR PREPARATIONS
- A01P3/00—Fungicides
- C—CHEMISTRY; METALLURGY
- C12—BIOCHEMISTRY; BEER; SPIRITS; WINE; VINEGAR; MICROBIOLOGY; ENZYMOLOGY; MUTATION OR GENETIC ENGINEERING
- C12N—MICROORGANISMS OR ENZYMES; COMPOSITIONS THEREOF; PROPAGATING, PRESERVING, OR MAINTAINING MICROORGANISMS; MUTATION OR GENETIC ENGINEERING; CULTURE MEDIA
- C12N1/00—Microorganisms, e.g. protozoa; Compositions thereof; Processes of propagating, maintaining or preserving microorganisms or compositions thereof; Processes of preparing or isolating a composition containing a microorganism; Culture media therefor
- C12N1/14—Fungi; Culture media therefor
- C—CHEMISTRY; METALLURGY
- C12—BIOCHEMISTRY; BEER; SPIRITS; WINE; VINEGAR; MICROBIOLOGY; ENZYMOLOGY; MUTATION OR GENETIC ENGINEERING
- C12N—MICROORGANISMS OR ENZYMES; COMPOSITIONS THEREOF; PROPAGATING, PRESERVING, OR MAINTAINING MICROORGANISMS; MUTATION OR GENETIC ENGINEERING; CULTURE MEDIA
- C12N1/00—Microorganisms, e.g. protozoa; Compositions thereof; Processes of propagating, maintaining or preserving microorganisms or compositions thereof; Processes of preparing or isolating a composition containing a microorganism; Culture media therefor
- C12N1/14—Fungi; Culture media therefor
- C12N1/145—Fungal isolates
- C—CHEMISTRY; METALLURGY
- C12—BIOCHEMISTRY; BEER; SPIRITS; WINE; VINEGAR; MICROBIOLOGY; ENZYMOLOGY; MUTATION OR GENETIC ENGINEERING
- C12R—INDEXING SCHEME ASSOCIATED WITH SUBCLASSES C12C - C12Q, RELATING TO MICROORGANISMS
- C12R2001/00—Microorganisms ; Processes using microorganisms
- C12R2001/645—Fungi ; Processes using fungi
- C12R2001/80—Penicillium
Landscapes
- Life Sciences & Earth Sciences (AREA)
- Engineering & Computer Science (AREA)
- Health & Medical Sciences (AREA)
- Zoology (AREA)
- Microbiology (AREA)
- Chemical & Material Sciences (AREA)
- Wood Science & Technology (AREA)
- Biotechnology (AREA)
- General Health & Medical Sciences (AREA)
- Mycology (AREA)
- Bioinformatics & Cheminformatics (AREA)
- Virology (AREA)
- Organic Chemistry (AREA)
- Genetics & Genomics (AREA)
- Pest Control & Pesticides (AREA)
- Environmental Sciences (AREA)
- Plant Pathology (AREA)
- Agronomy & Crop Science (AREA)
- Botany (AREA)
- Medicinal Chemistry (AREA)
- Tropical Medicine & Parasitology (AREA)
- Biomedical Technology (AREA)
- Biochemistry (AREA)
- General Engineering & Computer Science (AREA)
- Dentistry (AREA)
- General Chemical & Material Sciences (AREA)
- Chemical Kinetics & Catalysis (AREA)
- Agricultural Chemicals And Associated Chemicals (AREA)
Abstract
Description
Technical Field
The invention belongs to the technical field of plant disease and insect pest control, and particularly relates to a tea tree endophyte Penicillium ehrlichii and application thereof.
Background
Endophytes refer to groups of microorganisms that can live in the intercellular spaces and cells of various organs and tissues of plants and establish harmonious symbiotic relationships with plants, including bacteria, fungi, actinomycetes, and the like. This harmonious symbiotic relationship is manifested by its parasitism in the host plant during part or all of its life cycle and its temporary absence from pathogenicity to the plant. The endophyte is one of the components of the plant body and plays an important role in the functions of plant growth, biomass accumulation, carbon sequestration, bioremediation and the like.
The endophyte colonizes the body of the host plant, on one hand, can promote the growth of the plant, and on the other hand, can enhance the resistance of the host plant to biotic (phytopathogen, pest and the like) and abiotic stress. The endophyte of the plant can generate or promote host plants to generate a series of secondary metabolites under certain development stage and external environment, wherein a part of the secondary metabolites have high biological activity and wide application prospect, such as antibiotics, immunosuppressants and the like. The biological control mechanism of endophytes in plants includes antagonism (producing enzymes, antibiotics, bacteriocins and volatile substances) and induction of systemic disease resistance (inducing plants to produce polyphenol oxidase, peroxidase, phenylalanine ammonia lyase and superoxide dismutase).
Plant diseases are one of the main threats in agriculture and forestry production, and chemical control is a main means for plant diseases for a long time, but the defects of the chemical control are increasingly prominent, such as drug resistance of pathogenic bacteria, ecological environment pollution, human health threat and the like, so biological control becomes one of the important options which can be used for replacing chemical control at present. In addition, the separation of biocontrol endophyte strains with antagonistic action on pathogenic bacteria is a precondition and a basis for developing and utilizing biocontrol bacteria for preventing and treating plant diseases.
Various biocontrol mechanisms exist in biological control of plant endophytes, and the biocontrol mechanisms of different endophytes also have difference. The endophyte as a biocontrol bacterium has different action mechanisms in preventing and treating plant diseases and is mainly characterized in that: the secretion of antibacterial substances, competition for nutrients and ecological niches with pathogens, promotion of plant growth, induction of plant resistance system, etc. to inhibit the growth of pathogens. Endophytes are regarded as natural resources for biological control, are widely applied to green control of plant diseases and insect pests due to safety and high activity, and have wide application potential and development and application values.
Tea tree (Camellia sinensis) is a perennial woody plant and is an important economic crop in China. Tea is a natural health drink and is known as a health drink in the 21 st century. However, the tea production is seriously harmed by continuous pest and disease damage, and the traditional chemical control has hidden troubles on the quality and health safety of the tea, thereby causing certain negative effects on the tea industry. Biological pesticides (natural products such as microorganisms and plant sources) are used for replacing chemical pesticides to prevent and control tea garden diseases and insect pests, and the method has important significance for green, healthy and sustainable development of the tea industry. The endophyte has great potential as a potential biological control resource.
At present, the study on tea tree endophytes is started later and less. Meanwhile, the research reports of the prevention effect of tea tree diseases by using tea tree endophyte resources are less.
Disclosure of Invention
Aiming at the problems in the prior art, the invention provides an endophyte Penicillium ehrlichii of tea trees and application thereof, and aims to solve part of the problems in the prior art or at least alleviate part of the problems in the prior art.
The invention is realized in such a way that a tea tree endophyte Penicillium ehrlichii has a preservation number: CCTCC NO: M2021635, deposited at 31/5/2021 to China center for type culture Collection, address: wuhan university in Wuhan, China, culture name: penicillium ehrlichii Z19.
The invention also provides application of the tea tree endophyte Penicillium ehrlichii in preparation of a reagent for preventing and treating plant anthracnose.
Further, the plant anthracnose comprises at least one of tea anthracnose, melon anthracnose, pear anthracnose and apple anthracnose.
The invention also provides application of the tea tree endophyte Penicillium ehrlichii in preparation of a reagent for preventing and treating plant leaf spot.
Further, the plant leaf spot comprises at least one of tea leaf spot and curvularia leaf spot.
The invention also provides application of the tea tree endophyte Penicillium ehrlichii in preparation of a reagent for preventing and treating plant blight.
Further, the plant fusarium wilt comprises at least one of cotton fusarium wilt and watermelon fusarium wilt.
The invention also provides application of the tea tree endophyte Penicillium ehrlichii in preparation of a reagent for preventing and treating plant gray seedling diseases, sclerotinia or plant fruit diseases.
Further, the plant gray seedling disease comprises grape gray seedling disease, and the sclerotinia disease comprises sclerotinia rot of colza; the plant fruit disease comprises at least one of melon anthracnose, pear anthracnose and apple anthracnose.
The invention also provides the anti-microbial agent, which comprises the tea tree endophyte Penicillium ehrlichii.
The novel endophyte is separated from the tea plant body, is identified as Penicillium ehrlichii through morphology and molecular biology, and shows good antagonistic bacteriostatic activity on common pathogenic bacteria on several plants through biological activity evaluation. The strain can be used for biocontrol bacteria of plant pathogenic bacteria and is applied to green and safe prevention and control of plant diseases. Of course the application is not limited to just a few phytopathogens in the patent.
In summary, the advantages and positive effects of the invention are:
1. biological control
The endophyte strain Penicillium ehrlichii protected by the patent has good antagonistic activity to several plant pathogenic bacteria. Compared with the traditional chemical control, the biocontrol bacteria can safely, efficiently and pollution-free control plant diseases, reduce the pollution to the ecological environment, improve the quality safety of agricultural products and ensure the health of human beings.
2. Endophyte biocontrol strain
The novel endophyte Penicillium ehrlichii of the tea tree separated from the tea tree in the item is not reported to be applied as a biocontrol bacterium and used for controlling phytopathogen at present.
Drawings
Fig. 1 is the rate of inhibition of 10 plant pathogens by the endophytic fungus p.ehrlichii;
FIG. 2 shows the antibacterial effect of endophytic fungus P.ehrlichii on the hyphal growth of the pathogenic bacteria of melon anthrax for 7 d;
FIG. 3 shows the bacteriostatic effect of endophytic fungus P.ehrlichii on the hyphal growth of tea leaf roller spot primary fungus for 7 d;
FIG. 4 shows the antibacterial effect of endophytic fungus P.ehrlichii on the hyphal growth of anthracnose pathogen of pear for 7 d;
FIG. 5 shows the antibacterial effect of endophytic fungus P.ehrlichii on the hyphal growth of cotton wilt pathogenic bacteria for 7 d;
FIG. 6 shows the 7d bacteriostatic effect of endophytic fungus P.ehrlichii on the hyphal growth of apple anthracnose pathogen;
FIG. 7 shows the 7d bacteriostatic effect of endophytic fungus P.ehrlichii on the hypha growth of grape gray mold primula;
FIG. 8 shows the 7d bacteriostatic effect of endophytic fungus P.ehrlichii on the hyphal growth of rice curvularia lunata;
FIG. 9 shows the 7d bacteriostatic effect of endophytic fungus P.ehrlichii on the resistance of mycelial growth of Fusarium oxysporum f.sp.citrulli;
FIG. 10 shows the 7d bacteriostatic effect of endophytic fungus P.ehrlichii on antagonising sclerotinia sclerotiorum hypha growth;
fig. 11 shows the bacteriostatic effect of endophytic fungus p.ehrlichii on the hyphal growth of tea anthracnose pathogen for 7 days.
Detailed Description
In order to make the objects, technical solutions and advantages of the present invention more apparent, the present invention is further described in detail below with reference to examples, and the equipment and reagents used in the examples and test examples are commercially available without specific reference. The specific embodiments described herein are merely illustrative of the invention and are not intended to be limiting.
Various modifications to the precise description of the invention will be readily apparent to those skilled in the art from the information contained herein without departing from the spirit and scope of the appended claims. It is to be understood that the scope of the invention is not limited to the procedures, properties, or components defined, as these embodiments, as well as others described, are intended to be merely illustrative of particular aspects of the invention. Indeed, various modifications of the embodiments of the invention which are obvious to those skilled in the art or related fields are intended to be covered by the scope of the appended claims.
For a better understanding of the invention, and not as a limitation on the scope thereof, all numbers expressing quantities, percentages, and other numerical values used in this application are to be understood as being modified in all instances by the term "about". Accordingly, unless expressly indicated otherwise, the numerical parameters set forth in the specification and attached claims are approximations that may vary depending upon the desired properties sought to be obtained. At the very least, each numerical parameter should at least be construed in light of the number of reported significant digits and by applying ordinary rounding techniques. In the present invention, "about" means within 10%, preferably within 5% of a given value or range.
In the following examples of the present invention, the temperature is not particularly limited, and all of the conditions are normal temperature conditions. The normal temperature refers to the natural room temperature condition in four seasons, no additional cooling or heating treatment is carried out, and the normal temperature is generally controlled to be 10-30 ℃, preferably 15-25 ℃.
The invention discloses a tea tree endophyte Penicillium ehrlichii and application thereof, and the specific examples are shown in the following.
Example 1 isolation and identification of endophyte strains
Taking healthy tea tree rhizome and leaf tissues, cleaning soil on the surface of the healthy tea tree rhizome and leaf tissues with tap water, firstly soaking in 70% alcohol for 1min, then soaking in 3% sodium hypochlorite solution for 4min, then soaking in 70% alcohol for 1s, finally washing with sterile water for 5 times, sucking 100uL of sterile water washed for the last time, and coating the sterile water on a PDA culture medium to prepare a control culture medium.
Tissue isolation method: cutting tea tree tissue with sterilized surface into small blocks of 5mm by 5mm, attaching the cut section to PDA culture medium, culturing at constant temperature of 25 deg.C for 7d, observing every day, and picking out new hypha with bacteria transferring ring for individual culture.
ITS and 18S gene locus sequencing is carried out on the separated endophytic fungi, and BLAST comparison is carried out on a sequencing result on NCBI to obtain the name of a similar strain, namely Penicillium ehrlichii (Table 1).
TABLE 1 ITS sequencing identification results
Example 2 endophyte antagonism experiment
In this example, the endophytic fungus p.ehrlichii was used to perform plate experiments on 9 plant disease pathogens (melon anthracnose (Colletorichum lagenarium (Pass.) el. et Halst), tea leaf spot (pseudoalterotoperosis thae), pear anthracnose (collerichrichum gloeosporioides Penz.), cotton wilt (Fusarium oxysporum), apple anthracnose (Penz.) Penz. et sacc., grape gray mold (Botrytis cinerea Pers), curvularia leaf spot (Culvularia lunata), watermelon wilt (Fusarium oxysporum), rape sclerotia (sclerotium (Bary)) at different times and for growth, and the colony growth rates were calculated as follows:
1. plate confrontation method:
the method comprises the steps of carving a fungus cake with the radius of 5mm from the edge of a pathogenic bacterium colony, inoculating hypha downwards to the center point of a PDA culture medium plate, carving 4 endophyte P.ehrlichii fungus cakes by the same method, respectively inoculating the cakes in four directions 2.5cm away from the pathogenic bacterium cake, using a plate without the P.ehrlichii fungus cake as a contrast, culturing at the constant temperature of 25 ℃ for 7 days, measuring the diameter of the pathogenic bacterium colony every day, and calculating the bacteriostasis rate. The method for calculating the bacteriostasis rate comprises the following steps:
antagonistic bacteria inhibition ratio (%) ═ ((control group colony diameter-5) - (treatment group colony diameter-5))/(control group colony diameter-5)
2. The results of the confrontation experiment: research shows that the bacteriostasis rate of P.ehrlichi to 10 selected pathogenic bacteria is over 50 percent on the seventh day (figure 1), and the bacteriostasis rate to anthracnose is almost over 80 percent. The effect of endophytic fungus P.ehrlichii on the growth inhibition of hypha of 10 plant pathogenic bacteria is shown in fig. 2-11, wherein the upper part is a control group, and the lower part is a treatment group.
The above description is only for the purpose of illustrating the preferred embodiments of the present invention and is not to be construed as limiting the invention, and any modifications, equivalents and improvements made within the spirit and principle of the present invention are intended to be included within the scope of the present invention.
Claims (6)
1. Tea tree endophytePenicillium ehrlichiiThe preservation number is: CCTCC NO: M2021635.
2. The endophyte of Camellia sinensis as claimed in claim 1Penicillium ehrlichiiThe application in the preparation of the reagent for preventing and treating plant anthracnose; the plant anthracnose is at least one of tea anthracnose, melon anthracnose, pear anthracnose and apple anthracnose.
3. The endophyte of Camellia sinensis as claimed in claim 1Penicillium ehrlichiiThe application in the preparation of a reagent for preventing and treating plant leaf spot; the plant leaf spot is at least one of tea leaf spot and curvularia leaf spot of rice.
4. The endophyte of Camellia sinensis as claimed in claim 1Penicillium ehrlichiiThe application in the preparation of a reagent for preventing and treating the blight of plants; the plant fusarium wilt is at least one of cotton fusarium wilt and watermelon fusarium wilt.
5. The endophyte of Camellia sinensis as claimed in claim 1Penicillium ehrlichiiThe application in preparing the reagent for preventing and treating the plant gray seedling disease, the sclerotinia rot or the plant fruit disease; the plant gray seedling disease is grape gray seedling disease, and the sclerotinia rot is rape sclerotinia rot; the plant fruit disease is at least one of melon anthracnose, pear anthracnose and apple anthracnose.
6. A biological control agent is characterized in that: comprising the endophyte Penicillium ehrlichii of Camellia sinensis as claimed in claim 1.
Priority Applications (3)
| Application Number | Priority Date | Filing Date | Title |
|---|---|---|---|
| CN202110687884.2ACN113388529B (en) | 2021-06-21 | 2021-06-21 | Endophyte Penicillium ehrlichii of tea tree and application thereof |
| NL2029438ANL2029438B1 (en) | 2021-06-21 | 2021-10-15 | Strain of camellia sinensis endophyte penicillium ehrlichii and its application |
| US17/828,266US20220400685A1 (en) | 2021-06-21 | 2022-05-31 | Camellia sinensis endophyte penicillium ehrlichii and application thereof |
Applications Claiming Priority (1)
| Application Number | Priority Date | Filing Date | Title |
|---|---|---|---|
| CN202110687884.2ACN113388529B (en) | 2021-06-21 | 2021-06-21 | Endophyte Penicillium ehrlichii of tea tree and application thereof |
Publications (2)
| Publication Number | Publication Date |
|---|---|
| CN113388529A CN113388529A (en) | 2021-09-14 |
| CN113388529Btrue CN113388529B (en) | 2022-03-29 |
Family
ID=77623461
Family Applications (1)
| Application Number | Title | Priority Date | Filing Date |
|---|---|---|---|
| CN202110687884.2AActiveCN113388529B (en) | 2021-06-21 | 2021-06-21 | Endophyte Penicillium ehrlichii of tea tree and application thereof |
Country Status (3)
| Country | Link |
|---|---|
| US (1) | US20220400685A1 (en) |
| CN (1) | CN113388529B (en) |
| NL (1) | NL2029438B1 (en) |
Families Citing this family (9)
| Publication number | Priority date | Publication date | Assignee | Title |
|---|---|---|---|---|
| CN113388529B (en)* | 2021-06-21 | 2022-03-29 | 安徽农业大学 | Endophyte Penicillium ehrlichii of tea tree and application thereof |
| CN114561298B (en)* | 2022-03-02 | 2023-04-28 | 安徽农业大学 | Application and control method of Penicillium ellie in controlling plant pests |
| CN114672424B (en)* | 2022-05-12 | 2023-04-18 | 安徽农业大学 | Tea tree endophyte and application thereof in plant disease control |
| CN116083276B (en)* | 2022-09-09 | 2023-11-10 | 华南师大(清远)科技创新研究院有限公司 | Peanut endophytic bacteria and application thereof in plant disease and pest control |
| CN115651851B (en)* | 2022-12-26 | 2023-03-21 | 中国热带农业科学院南亚热带作物研究所 | A kind of water core disease pineapple endophyte and its application in plant disease control |
| CN116621349B (en)* | 2023-04-26 | 2025-06-10 | 安徽农业大学 | Application of ehrlichia in degrading glufosinate-ammonium and microbial agent |
| CN117264778B (en)* | 2023-08-24 | 2024-05-28 | 安徽农业大学 | Fucus fungus and application thereof |
| CN118064278A (en)* | 2024-02-21 | 2024-05-24 | 安徽农业大学 | Application of Penicillium erlichii or its bacterial agent as disease resistance inducer in broad-spectrum control of tea tree fungal diseases |
| CN119214172B (en)* | 2024-12-05 | 2025-03-18 | 海南热带海洋学院 | A biocontrol marine-derived Penicillium and its application |
Citations (6)
| Publication number | Priority date | Publication date | Assignee | Title |
|---|---|---|---|---|
| WO2005095580A1 (en)* | 2004-03-30 | 2005-10-13 | Idemitsu Kosan Co., Ltd. | Microorganism controlling plant disease and plant disease controlling agent using the same |
| CN107629985A (en)* | 2017-11-01 | 2018-01-26 | 广州市林业和园林科学研究院 | One plant of endophytic bacterium for having antagonism to plant pathogenic fungi |
| CN107736379A (en)* | 2017-11-01 | 2018-02-27 | 广州市林业和园林科学研究院 | Application of the bacillus amyloliquefaciens in fungal diseases of plants is prevented and treated |
| WO2018083577A1 (en)* | 2016-11-04 | 2018-05-11 | Upl Ltd | Fungicidal combinations |
| CN109234170A (en)* | 2018-08-31 | 2019-01-18 | 浙江师范大学 | Strain of Penicillium sp. Pe-8 and its application |
| CN110317747A (en)* | 2019-06-04 | 2019-10-11 | 华南农业大学 | A kind of bacillus amyloliquefaciens JT68 and its application in prevention and treatment tea anthracnose |
Family Cites Families (7)
| Publication number | Priority date | Publication date | Assignee | Title |
|---|---|---|---|---|
| EP2177600B1 (en)* | 2003-10-29 | 2013-09-18 | Kureha Corporation | Fungus having activity of controlling disease of gramineous plant, controlling agent using the same, method of controlling and biological material |
| JP2009221132A (en)* | 2008-03-14 | 2009-10-01 | Idemitsu Kosan Co Ltd | Agent for controlling disease and insect damage for agricultural/horticultural plants |
| CN109112069B (en)* | 2017-06-23 | 2021-09-24 | 沈阳药科大学 | A kind of biocontrol endophytic fungi and its application |
| CN108546651B (en)* | 2018-04-24 | 2020-11-10 | 广东立威化工有限公司 | Endophytic fungus 2cpe-1 of mangrove plant and its fermentation broth and application |
| CN111004726B (en)* | 2019-12-25 | 2021-05-14 | 浙江大学 | Penicillium with bacteriostatic action and application |
| CN112094755B (en)* | 2020-09-22 | 2022-07-15 | 福建省亚热带植物研究所 | Penicillium oxalicum HY181-2, preparation method and application thereof |
| CN113388529B (en)* | 2021-06-21 | 2022-03-29 | 安徽农业大学 | Endophyte Penicillium ehrlichii of tea tree and application thereof |
- 2021
- 2021-06-21CNCN202110687884.2Apatent/CN113388529B/enactiveActive
- 2021-10-15NLNL2029438Apatent/NL2029438B1/ennot_activeIP Right Cessation
- 2022
- 2022-05-31USUS17/828,266patent/US20220400685A1/ennot_activeAbandoned
Patent Citations (6)
| Publication number | Priority date | Publication date | Assignee | Title |
|---|---|---|---|---|
| WO2005095580A1 (en)* | 2004-03-30 | 2005-10-13 | Idemitsu Kosan Co., Ltd. | Microorganism controlling plant disease and plant disease controlling agent using the same |
| WO2018083577A1 (en)* | 2016-11-04 | 2018-05-11 | Upl Ltd | Fungicidal combinations |
| CN107629985A (en)* | 2017-11-01 | 2018-01-26 | 广州市林业和园林科学研究院 | One plant of endophytic bacterium for having antagonism to plant pathogenic fungi |
| CN107736379A (en)* | 2017-11-01 | 2018-02-27 | 广州市林业和园林科学研究院 | Application of the bacillus amyloliquefaciens in fungal diseases of plants is prevented and treated |
| CN109234170A (en)* | 2018-08-31 | 2019-01-18 | 浙江师范大学 | Strain of Penicillium sp. Pe-8 and its application |
| CN110317747A (en)* | 2019-06-04 | 2019-10-11 | 华南农业大学 | A kind of bacillus amyloliquefaciens JT68 and its application in prevention and treatment tea anthracnose |
Non-Patent Citations (2)
| Title |
|---|
| "The Plant Growth-promoting Fungus Penicillium spp. GP15-1 Enhances Growth and Confers Protection against Damping-off and Anthracnose in the Cucumber";Md. Motaher Hossain et al.;《Journal Of Oleo Science》;20141231;第63卷(第4期);第391-400页* |
| "防治脐橙炭疽病生防菌的筛选";张晓媛等;《江苏农业科学》;20161231;第44卷(第1期);第152-154页* |
Also Published As
| Publication number | Publication date |
|---|---|
| CN113388529A (en) | 2021-09-14 |
| NL2029438B1 (en) | 2022-12-30 |
| US20220400685A1 (en) | 2022-12-22 |
Similar Documents
| Publication | Publication Date | Title |
|---|---|---|
| CN113388529B (en) | Endophyte Penicillium ehrlichii of tea tree and application thereof | |
| CN102485880B (en) | A strain of Bacillus amyloliquefaciens and its application | |
| CN108641981B (en) | Biocontrol bacillus identification and application | |
| CN107736379B (en) | Application of bacillus amyloliquefaciens in preventing and treating plant fungal diseases | |
| CN110066756B (en) | Paenibacillus kribbensis and preparation and application thereof | |
| CN102433282A (en) | Bacillus subtilis NB12 and culture method and application thereof | |
| CN105734000A (en) | Paenibacillus polymyxa NSY50 with capabilities of promoting growth and preventing diseases | |
| CN113817642B (en) | Bacillus bailii YJ02, microbial preparation and application thereof | |
| CN109456921B (en) | Paenibacillus polymyxa, application thereof, microbial agent, powder and granules | |
| CN104403970B (en) | A kind of bacillus subtilis and the application in control of plant disease thereof | |
| CN111187741B (en) | Biocontrol pseudomonas and application thereof | |
| CN113699065A (en) | Bacillus vallismortis and application thereof | |
| KR20080045346A (en) | Novel Bacillus subtilis M27 strain and method for controlling plant fungal disease comprising the active ingredient | |
| CN101531971A (en) | Bacillus subtilis and application thereof in prevention and treatment of continuous cropping obstacle of greenhouse vegetable | |
| CN103952328A (en) | Bacillus subtilis strain A33, microbial inoculum and preparation method and application thereof | |
| CN113444651B (en) | Saffron endophytic fungus and application thereof in preventing and treating bulb rot | |
| CN112342173A (en) | Bacillus belgii and application thereof | |
| CN111778174A (en) | A kind of Bacillus subtilis with inhibitory effect on citrus sand skin disease and its screening method | |
| CN111876361B (en) | Biocontrol Paenibacillus separated from healthy hickory woodland and application thereof | |
| WO2016150152A1 (en) | Preparation method for bacillus coagulans bacterial suspension | |
| CN107828697B (en) | Paenibacillus polymyxa biocontrol strain AF01 and application thereof | |
| CN101942403B (en) | Bacillus pumilus as well as culture method and application thereof | |
| CN102965299A (en) | Fermentation process of Bacillus pumilus LD-b1 and its application in control of plant diseases | |
| CN107760630B (en) | Bacillus methylotrophicus B18, microbial inoculum and application thereof | |
| CN107629985B (en) | Plant endophytic bacterium with antagonistic effect on plant pathogenic fungi |
Legal Events
| Date | Code | Title | Description |
|---|---|---|---|
| PB01 | Publication | ||
| PB01 | Publication | ||
| SE01 | Entry into force of request for substantive examination | ||
| SE01 | Entry into force of request for substantive examination | ||
| GR01 | Patent grant | ||
| GR01 | Patent grant |